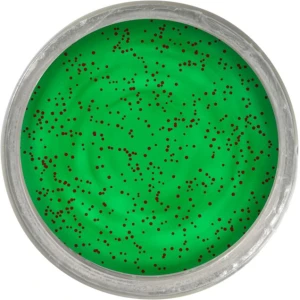

1 (0.132)
SELECT data
FROM `oc_session`
WHERE session_id = '27ecbfd24648b8c336b70deaf4'
/var/www/clients/client1/web1/web/system/library/session/db.php:24
2 (0.148)
SELECT *
FROM oc_url_alias
WHERE keyword = 'nade-si-momeli'
/var/www/clients/client1/web1/web/catalog/controller/common/seo_url.php:48
3 (0.128)
SELECT *
FROM oc_url_alias
WHERE keyword = 'atractanti-rapitori'
/var/www/clients/client1/web1/web/catalog/controller/common/seo_url.php:48
4 (0.077)
SELECT *
FROM oc_url_alias
WHERE keyword = 'pasta-berkley-powerbait-trout-dough-fruits-floating--apple-jack--50g.html'
/var/www/clients/client1/web1/web/catalog/controller/common/seo_url.php:48
5 (0.122)
SELECT *
FROM `oc_module`
WHERE `code` = 'similar_products'
ORDER BY `name`
/var/www/clients/client1/web1/web/catalog/model/extension/module.php:5
6 (0.173)
SELECT *
FROM `oc_product_locatie`
WHERE product_id = '233377' AND baza_date LIKE 'magazin_ffb'
ORDER BY LENGTH(camera), camera ASC, LENGTH(rand), rand ASC, LENGTH(raft), raft ASC, LENGTH(alveola), alveola ASC
/var/www/clients/client1/web1/web/catalog/model/catalog/product.php:22
7 (0.106)
SELECT *
FROM `oc_product_locatie`
WHERE product_id = '233377' AND baza_date LIKE 'magazin_claumar'
ORDER BY LENGTH(camera), camera ASC, LENGTH(rand), rand ASC, LENGTH(raft), raft ASC, LENGTH(alveola), alveola ASC
/var/www/clients/client1/web1/web/catalog/model/catalog/product.php:22
8 (0.121)
SELECT *
FROM oc_stock_status
WHERE furnizor LIKE '%PURE FISHING EUROPE SAS%' AND language_id = '2'
/var/www/clients/client1/web1/web/catalog/model/catalog/product.php:132
9 (0.211)
SELECT COUNT(1) AS total, rating
FROM `oc_review`
WHERE `product_id` = '233377' AND status=1 GROUP BY rating
ORDER BY rating ASC
/var/www/clients/client1/web1/web/catalog/model/catalog/review.php:125
10 (0.095)
SELECT COUNT(1) AS total
FROM `oc_review`
WHERE `product_id` = '233377' AND status=1 AND verificat = '1' GROUP BY product_id
/var/www/clients/client1/web1/web/catalog/model/catalog/review.php:134
11 (0.202)
SELECT r.review_id, r.author, r.rating, r.text, p.product_id, pd.name, p.price, p.image, r.date_added, r.verificat, r.apreciat, r.depreciat
FROM oc_review r
LEFT JOIN oc_product p ON (r.product_id = p.product_id)
LEFT JOIN oc_product_description pd ON (p.product_id = pd.product_id)
WHERE p.product_id = '233377' AND p.date_available <= NOW() AND p.status = '1' AND r.status = '1' AND pd.language_id = '2'
ORDER BY r.date_added DESC LIMIT 0,100
/var/www/clients/client1/web1/web/catalog/model/catalog/review.php:170
12 (0.247)
SELECT *
FROM oc_product_related pr
LEFT JOIN oc_product p ON (pr.related_id = p.product_id)
LEFT JOIN oc_product_to_store p2s ON (p.product_id = p2s.product_id)
WHERE pr.product_id = '233377' AND p.status = '1' AND p2s.store_id = '0'
/var/www/clients/client1/web1/web/catalog/model/catalog/product.php:1420
13 (0.116)
SELECT *
FROM oc_stock_status
WHERE furnizor LIKE '%PURE FISHING EUROPE SAS%' AND language_id = '2'
/var/www/clients/client1/web1/web/catalog/model/catalog/product.php:132
14 (0.118)
SELECT *
FROM oc_stock_status
WHERE furnizor LIKE '%PURE FISHING EUROPE SAS%' AND language_id = '2'
/var/www/clients/client1/web1/web/catalog/model/catalog/product.php:132
15 (0.148)
SELECT `pd`.*
FROM `oc_product_recurring` `pp` JOIN `oc_recurring_description` `pd` ON `pd`.`language_id` = 2 AND `pd`.`recurring_id` = `pp`.`recurring_id` JOIN `oc_recurring` `p` ON `p`.`recurring_id` = `pd`.`recurring_id`
WHERE `product_id` = 233377 AND `status` = 1 AND `customer_group_id` = 1
ORDER BY `sort_order` ASC
/var/www/clients/client1/web1/web/catalog/model/catalog/product.php:1730
16 (0.168)
SELECT *
FROM `oc_pb_bundles`
WHERE
`products` != ''
AND `status`= '1' AND type = '1'
AND `date_available` <= NOW()
AND `customer_type` = 0 AND `products_show` LIKE '%"233377"%' LIMIT 0, 1000
/var/www/clients/client1/web1/web/catalog/model/module/productbundles.php:106
17 (0.174)
SELECT *
FROM `oc_pb_bundles`
WHERE
`products` != ''
AND `status`= '1' AND type = '0'
AND `date_available` <= NOW()
AND `customer_type` = 0 AND `products_show` LIKE '%"233377"%' LIMIT 0, 1000
/var/www/clients/client1/web1/web/catalog/model/module/product_recomandate.php:106
18 (0.156)
SELECT *
FROM oc_product
WHERE product_id = '233377'
/var/www/clients/client1/web1/web/catalog/model/module/similar_products.php:179
19 (0.141)
SELECT *
FROM oc_banner_image bi
LEFT JOIN oc_banner_image_description bid ON (bi.banner_image_id = bid.banner_image_id)
WHERE bi.banner_id = '24' AND bid.language_id = '2'
ORDER BY bi.sort_order ASC
/var/www/clients/client1/web1/web/catalog/model/design/banner.php:4
20 (0.106)
SELECT *
FROM `oc_mxt_setting`
WHERE store_id = '0' AND name = 'lichidare_stoc'
/var/www/clients/client1/web1/web/catalog/model/catalog/category.php:37
21 (0.122)
SELECT *
FROM oc_module
WHERE module_id = '1192'
/var/www/clients/client1/web1/web/catalog/model/extension/module.php:16